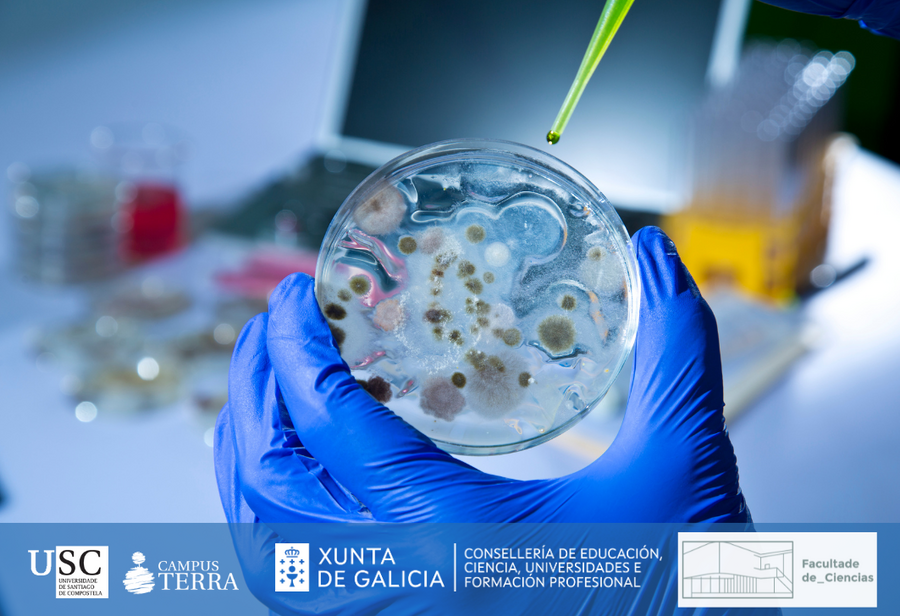
Imaxe do curso

Edificio de Laboratorios
Organizador: Facultade de Ciencias
O cambio climático está a causar a aparición de patóxenos emerxentes. Estes, representan un risco para a saúde pública así como perdas económicas para as empresas alimentarias.
Este curso, eminentemente práctico, mostrará tanto aos axentes do sector productivo como ao PDI e investigadores as últimas técnicas moleculares dispoñibles para unha detección rápida de estes patóxenos na propia industria alimentaria. Para iso, usarase como modelo o patóxeno emerxente Vibrio spp. O programa do curso, centrarase en mostrar os métodos normalizados dependentes de cultivo para a detección de Vibrio spp. en alimentos, métodos moleculares dirixidos para a detección de Vibrio spp. (qPCR vs LAMP) e métodos de secuenciación masiva para a detección de patóxenos emerxentes.
O horario deste curso, impartido por Alejandro Garrido Maestu e coordinado por Nerea González Rodríguez, será de 09:00 a 14:00 horas e impartirase no Edificio de Laboratorios da Facultade de Ciencias.
As persoas interesadas xa poden realizar a súa inscrición en liña.
